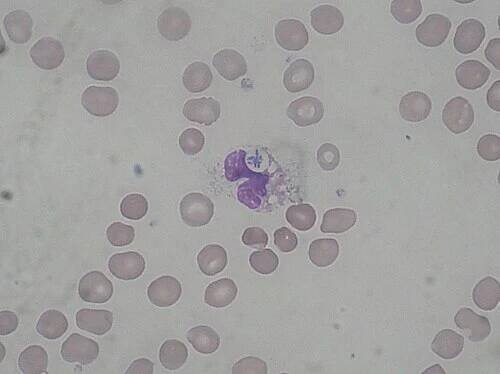

Pseudomonas
Bakterie
Pseudomonas (též pseudomonáda) je rod gramnegativních bakterií ze skupiny Gammaproteobacteria. V přírodě jsou velice hojné a díky své přizpůsobivosti osídlují velmi rozmanitá stanoviště. Některé druhy způsobují i onemocnění rostlin a živočichů včetně člověka; nejnebezpečnějším původcem lidských onemocnění mezi nimi je Pseudomonas aeruginosa. Co se týká vlastností… Wikipedia
Lidé také hledají
Pseudomonas – Wikipedie
Pseudomonas (též pseudomonáda) je rod gramnegativních bakterií ze skupiny Gammaproteobacteria. V přírodě jsou velice hojné a díky své přizpůsobivosti osídlují velmi rozmanitá stanoviště.
Pseudomonadota – Wikipedie
Pseudomonadota [1 ] [2 ], dříve Proteobacteria (někdy počeštěně proteobakterie) je velký kmen (v některých systémech oddělení) bakterií z říše Pseudomonadati. [3 ] K proteobakteriím patří mnoho patogenních druhů, jako Escherichia…
Neobsahuje pseudomonádaMusí obsahovat pseudomonáda
Pseudomonas aeruginosa – Wikipedie
Bacterium pyocyaneum) je pohyblivá gramnegativní bakterie se slizovou vrstvou patřící do skupiny fluorescenčních pseudomonád.
Pseudomonas | Medicína, nemoci, studium na 1. LF UK
Pseudomonas aeruginosa (pseudomonáda) je gramnegativní bakterie, která patří mezi původce některých respiračních a močových infekcí. Bakterie je typickým nozokomiálním patogenem, což znamená, že s oblibou vyvolává infekce u pacientů…
Pseudomonádové infekce | Medicína, nemoci, studium na 1.
Pseudomonádové infekce jsou poměrně závažné typy infekčních onemocnění, které jsou způsobeny bakteriemi ze skupiny pseudomonád, poměrně často Pseudomonas aeruginosa [eruginóza].
Wikipedie:Článek týdne/2022/27 – Wikipedie
Pseudomonas (též pseudomonáda) je rod gramnegativních bakterií ze skupiny Gammaproteobacteria. V přírodě jsou velice hojné a díky své přizpůsobivosti osídlují velmi rozmanitá stanoviště.
odkazuje na služby nejen od Seznam.cz.
© 1996–2025 Seznam.cz, a.s.